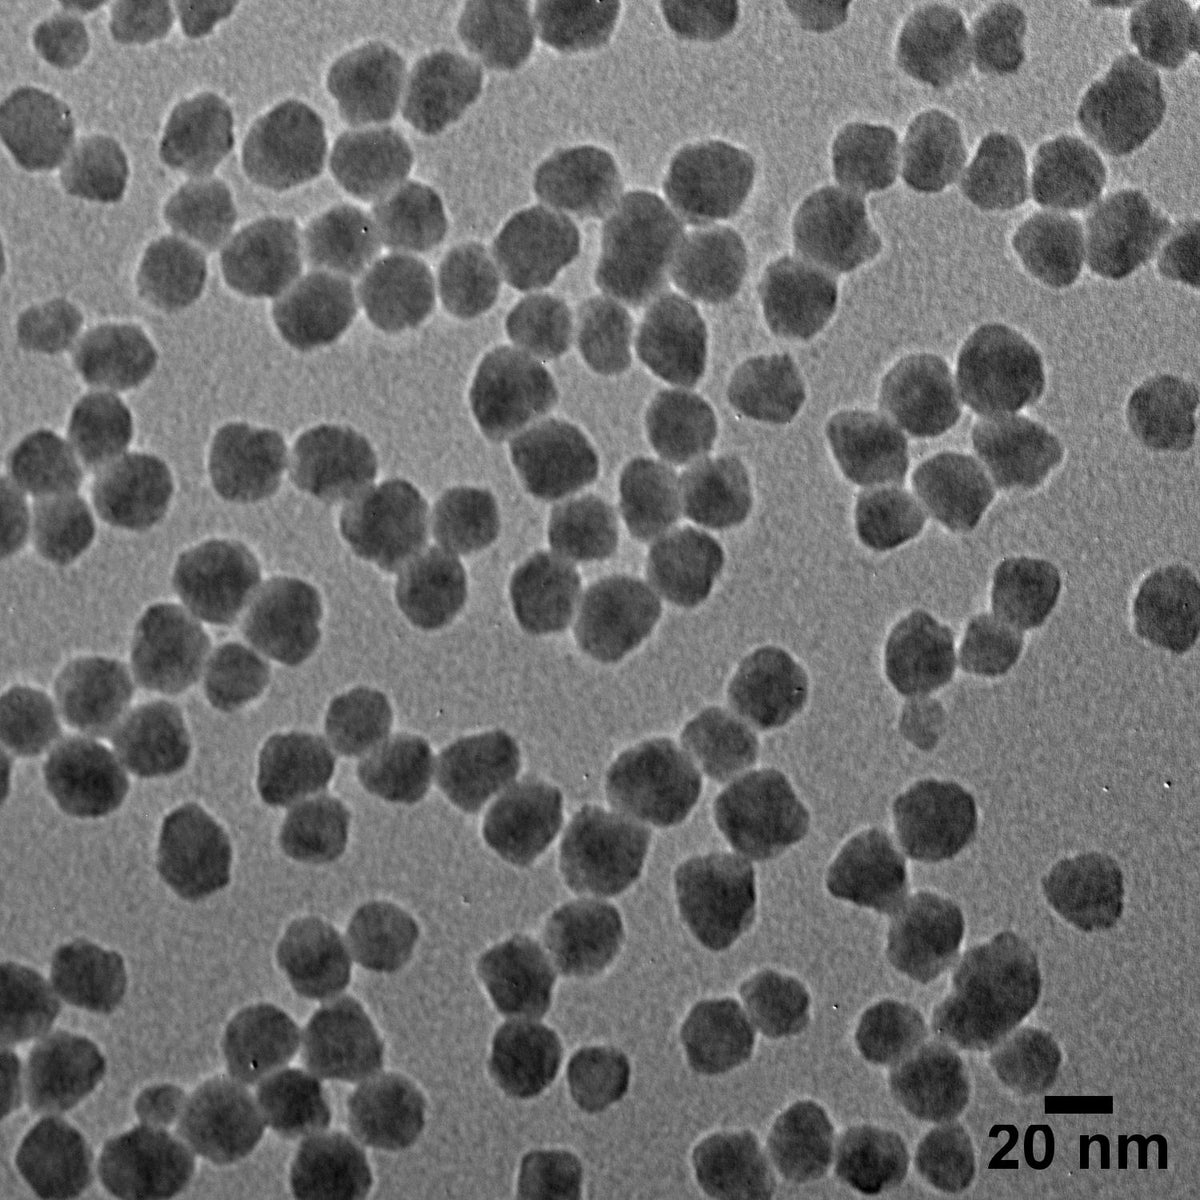

Description
As a global leader in silica nanoparticle production, AP USA specializes in providing high-purity and monodisperse nanomaterials – delivering the quality you need for consistent results.
Spherical Silica Nanoparticles combine biocompatibility, unique optical properties, and versatile surface functionalization capabilities. These nanoparticles are useful in a broad range of applications from nanomedicine, targeted drug delivery, UV-scattering, catalysis, DNA/RNA extraction, particle size references, and more.
AP USA provides high quality nanomaterials that are precisely engineered and highly characterized. All our products are supplied with a batch-specific Certificate of Analysis including characterization data such as TEM, DLS, Zeta, and UV-Vis.
| Overview | ||
|---|---|---|
| Surface | Silica | Silica, Aminated |
| Description | Ready-to-use suspension for surface modification or deposition. | Conjugatable surface. Ready-to-use suspension for surface modification or deposition. |
| Solvent | USP Purified Water | Ethanol |
| Surface chemistry | Silanol | Amine |
| Specifications | ||
| Surface | Silica | Silica, Aminated |
| TEM Diameter | 20, 50, 60, 80, 100, 120, 200, 300, 500 ± 4 nm | 20, 50, 60, 80, 100, 120, 200, 300, 500 ± 4 nm |
| CV | ≤ 15% | ≤ 15% |
| Documents | ||
| Surface | Silica | Silica, Aminated |
| Example Certificate of Analysis (CoA) | Download | Download |
| Safety Data Sheet (SDS) | 5 mg/mL (NanoXact) | 5 mg/mL (NanoXact) |
| Storage & Handling | Download | Download |
| Expected Ranges | ||
| Surface | Silica | Silica, Aminated |
| Zeta potential | ≤ –25 mV | ≥ 20 mV |
| pH of solution | 7.0–11.0 | N/A |